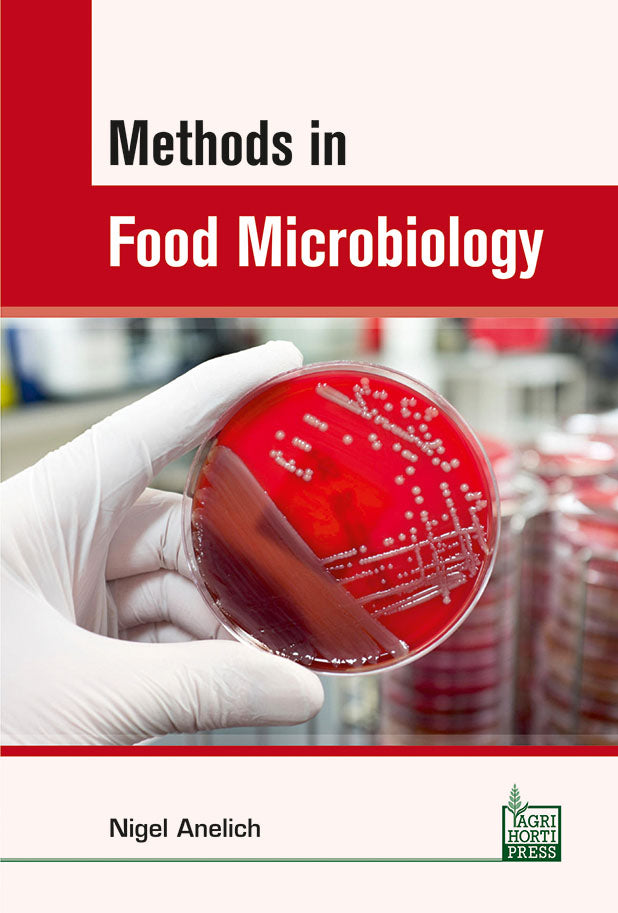
Methods in Food Microbiology By Nigel Anelich

1
/
of
1
Methods in Food Microbiology By Nigel Anelich
Methods in Food Microbiology By Nigel Anelich
Regular price
Rs. 1,636.00
Regular price
Rs. 1,995.00
Sale price
Rs. 1,636.00
Shipping calculated at checkout.
No reviews
Quantity
Couldn't load pickup availability
Product details
Publisher : Agri Horti Press
Author : Nigel Anelich
Language : English
Edition : Latest By Publishers
Book Cover : Hard Back
ISBN : 9789383285495
Table of Content
Dr. Nigel Anelich Ph.D. is experienced food microbiologist and Former Faculty of Food Microbiology in the Department of Food Science and Nutrition College of Agriculture at the Jijiga University Godey Town Ethiopia.
Materials
Materials
Paper
Shipping & Refunds
Shipping & Refunds
Share
1
/
of
4